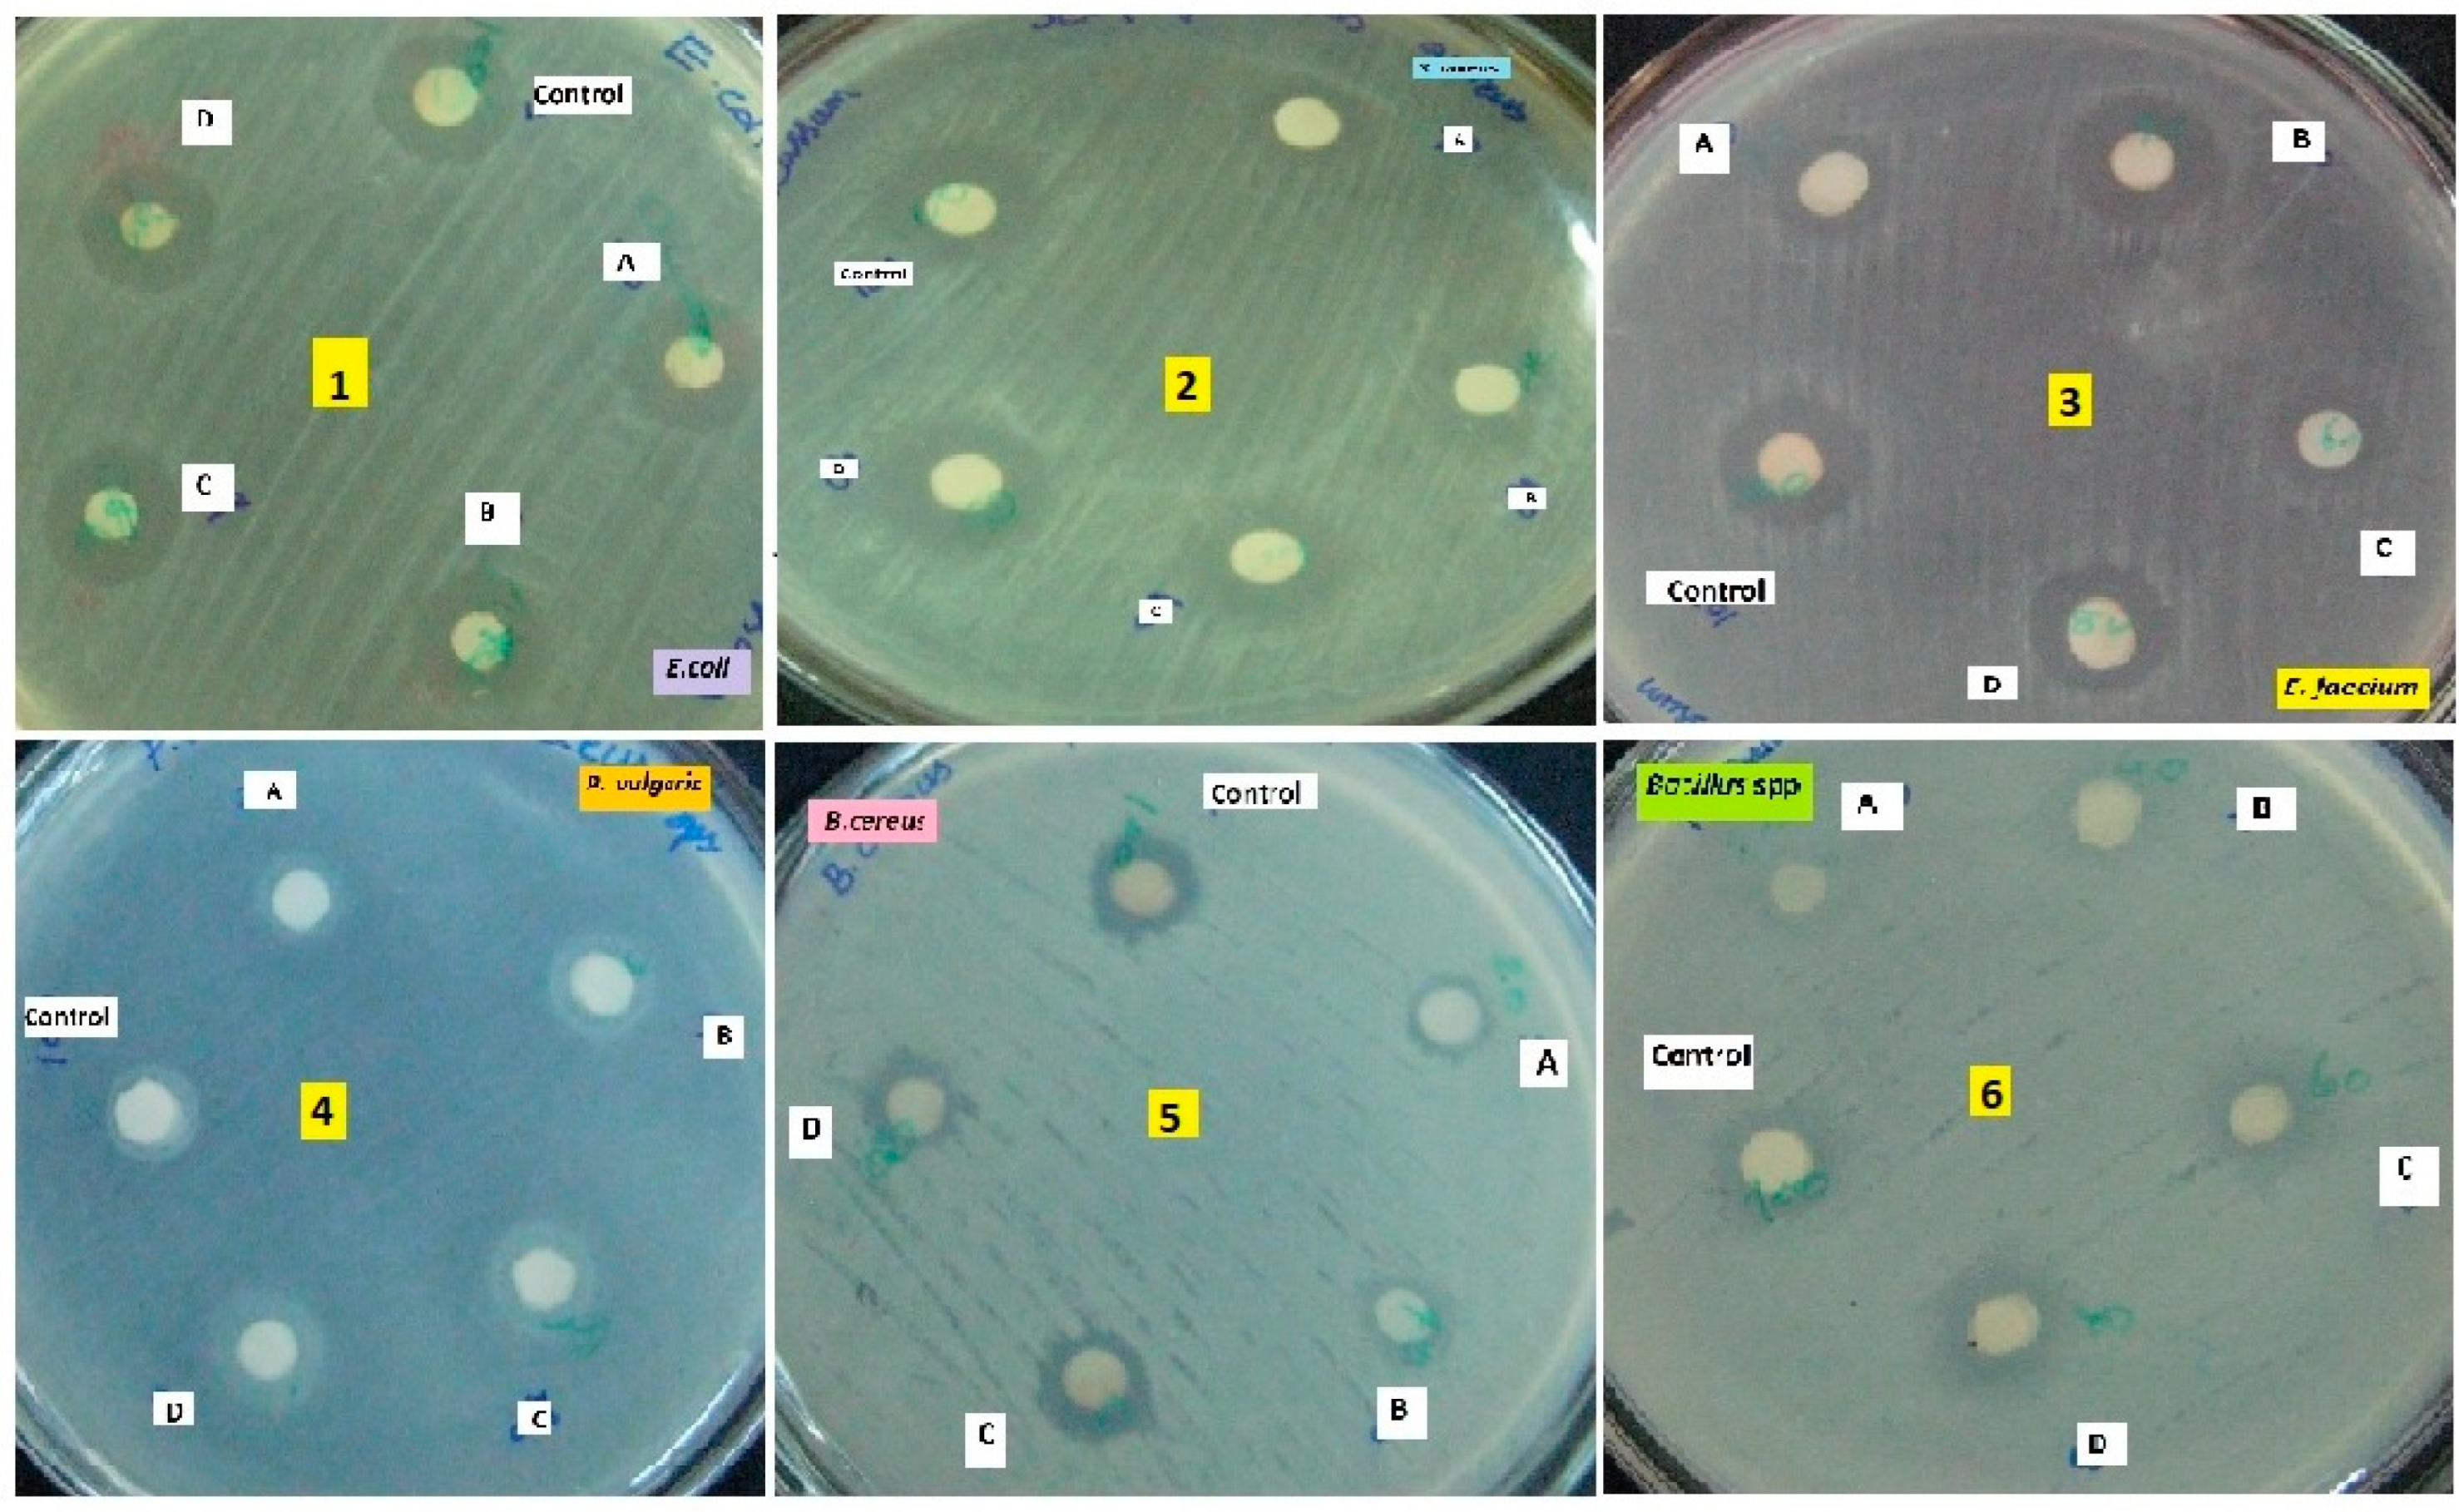

Submitted:
30 April 2024
Posted:
07 May 2024
You are already at the latest version
Abstract
Keywords:
1. Introduction
2. Results
2.1. Extraction of Symbiotic Bacteria
2.2. Bacterial Identification by 16S rRNA
2.3. Functional Group Analysis by FTIR
2.4. Secondary Chemical Compound Analyses for Symbiotic Bacterial in the Ethyl Acetate Crude Extract
| S. No. | R. Time | % of area | Compound name | Biological activities | Reference |
|---|---|---|---|---|---|
| 1 | 5.631 | 3.89 | Nonanoic acid derivatives | Antimicrobial properties | [17] |
| 2 | 5.823 | 4.27 | Paromycin | Antibacterial agents | [18] |
| 3 | 7.428 | 42.01 | Pyrrolidinone | Bioactive compounds | [19] |
| 4 | 8.848 | 3.98 | Octodecanal derivatives | Bioactive compounds | [20] |
| 5 | 13.198 | 4.53 | Trioxa-5-aza-1-silabicyclo | Anti-microbial compunds | [21] |
| 6 | 15.671 | 26.78 | 4-Octadecenal | Antifungal activity | [22] |
| 7 | 22.981 | 2.84 | Cyclopentanetridecanoic acid, Methylester | antimicrobial peptide | [23] |
| 8 | 23.978 | 4.629 | Oleic Acid | Antifungal compound | [24] |
| 9 | 31.98 | 1.876 | 1,2-benzenedicarboxylicacid | Bioactive molecules | [25] |
| S.No | R.Time | % of area | Compound name | Biological activities | Reference |
|---|---|---|---|---|---|
| 1 | 6.328 | 2.95 | Indole-3-acetic acid, methyl ester | Bioactive compound | [26] |
| 2 | 7.810 | 59.43 | Piperidinol derivatives | Antimicrobial agents | [27] |
| 3 | 8.302 | 5.78 | Phthalic acid | Bioactive compound | [28] |
| 4 | 12.816 | 5.91 | 1-Tetradecanol | Bioactive compound | [29] |
| 5 | 15.114 | 49.43 | Nemorosonol | Bioactive metabolites | [30] |
| 6 | 16.831 | 5.187 | octahydro-7-methyl-3-methylene | Insecticidal activity | [31] |
| 7 | 20.302 | 3.651 | 1-eicosanol | Bioactive compound | [32] |
| 8 | 25.220 | 2.284 | Octadecanoic acid, Methylester | Antimicrobial activity | [33] |
| 9 | 26.897 | 1.211 | unsaturated fatty acids | Anti-inflammation | [34] |
2.5. Antibacterial Activities of Symbiotic Bacteria
3. Discussion
4. Materials and Methods
4.1. Chemicals and Media
4.2. Identification, Extraction and Molecular Characterization of Symbiotic Bacteria
4.4. Extraction of Bioactive Crude Compound from Symbiotic Bacteria Using Ethyl Acetate
4.5. Purification of Bioactive Compound
4.6. FT-IR and GC-MS Analysis
4.7. Antibacterial Assay
4.5. Statistics
5. Conclusion
Author Contributions
Institutional Review Board Statement
Informed Consent Statement
Data Availability Statement
Conflicts of Interest
References
- Chandrakasan, G.; Rodríguez-Hernández, A.-I.; López-Cuellar, M.d.R.; Palma-Rodríguez, H.-M.; Chavarría-Hernández, N. Bacteriocin encapsulation for food and pharmaceutical applications: advances in the past 20 years. Biotechnol. Lett. 2019, 41, 453–469. [CrossRef]
- Newman, D.J.; Cragg, G.M. Natural Products As Sources of New Drugs over the 30 Years from 1981 to 2010. J. Nat. Prod. 2012, 75, 311–335. [CrossRef]
- Dongjin, J.; Youngkeun, Y.; Kang, G.H.; Choi, Y.H.; Kim, P.; Baek, N.I.; et al. Identification of an antibacterial compound, benzylideneacetone, from Xenorhabdus nematophila against major plant-pathogenic bacteria. FEMS Microbiol. Lett. 2004, 10-15.
- Bode, H.B. Entomopathogenic bacteria as a source of secondary metabolites. Curr. Opin. Chem. Biol. 2009, 13, 224–230. [CrossRef]
- Shi, Y.-M.; Hirschmann, M.; Shi, Y.-N.; Ahmed, S.; Abebew, D.; Tobias, N.J.; Grun, P.; Crames, J.J.; Poeschel, L.; Kuttenlochner, W.; et al. Global analysis of biosynthetic gene clusters reveals conserved and unique natural products in entomopathogenic nematode-symbiotic bacteria. Nat. Chem. 2022, 14, 701–+. [CrossRef]
- Boemare, N. Biology, taxonomy and systematics of Photorhabdus and Xenorhabdus. Entomopathogenic nematology, 2002, pp. 35-56. CABI Publishing, CAB International, Wallingford UK.
- Hazir, S.; Stackebrandt, E.; Lang, E.; Schumann, P.; Ehlers, R.-U.; Keskin, N. Two new Subspecies of Photorhabdus luminescens, Isolated from Heterorhabditis bacteriophora (Nematoda: Heterorhabditidae): Photorhabdus luminescens subsp. kayaii subsp. nov. and Photorhabdus luminescens subsp. thracensis subsp. nov.. Syst. Appl. Microbiol. 2004, 27, 36–42. [CrossRef]
- Loulou, A.; Mastore, M.; Caramella, S.; Bhat, A.H.; Brivio, M.F.; Machado, R.A.R.; Kallel, S. Entomopathogenic potential of bacteria associated with soil-borne nematodes and insect immune responses to their infection. PLOS ONE 2023, 18, e0280675. [CrossRef]
- Shapiro-Ilan, D.I.; Hazir, S.; Glaser, I. 2020. Advances in Use of Entomopathogenic Nematodes in Integrated Pest Management. In Integrated Management of Insect Pests: Current and Future Developments, 2020, pp. 91-105. Burleigh Dodds Science Publishing.
- Abd-Elgawad, M.M.M. Xenorhabdus spp.: An Overview of the Useful Facets of Mutualistic Bacteria of Entomopathogenic Nematodes. Life 2022, 12, 1360. [CrossRef]
- Yimthin, T.; Fukruksa, C.; Muangpat, P.; Dumidae, A.; Wattanachaiyingcharoen, W.; Vitta, A.; Thanwisai, A. A study on Xenorhabdus and Photorhabdus isolates from Northeastern Thailand: Identification, antibacterial activity, and association with entomopathogenic nematode hosts. PLOS ONE 2021, 16, e0255943. [CrossRef]
- Wang, Y.; Fang, X.; Cheng, Y.; Zhang, X. Manipulation of pH Shift to Enhance the Growth and Antibiotic Activity ofXenorhabdus nematophila. J. Biomed. Biotechnol. 2011, 2011, 1–9. [CrossRef]
- Lulamba, T.E.; Green, E.; Serepa-Dlamini, M.H. Photorhabdus sp. ETL Antimicrobial Properties and Characterization of Its Secondary Metabolites by Gas Chromatography–Mass Spectrometry. Life 2021, 11, 787. [CrossRef]
- Chandrakasan, G.; Seetharaman, P.; Gnanasekar, S.; Kadarkarai, M.; Sivaperumal, S. Xenorhabdus stockiae KT835471-mediated feasible biosynthesis of metal nanoparticles for their antibacterial and cytotoxic activities. Artif. Cells, Nanomedicine, Biotechnol. 2017, 45, 1675–1684. [CrossRef]
- Heermann, R.; Fuchs, T.M. Comparative analysis of the Photorhabdus luminescens and the Yersinia enterocolitica genomes: uncovering candidate genes involved in insect pathogenicity. BMC Genom. 2008, 9, 40–40. [CrossRef]
- Webster, J.M.; Chen, G.; Hu, K.; Li, J. Bacterial metabolites. Entomopathogenic Nematology, 2002, pp. 99-114. CABI Publishing, CAB International, Wallingford, UK.
- Sahin, N.; Kula, I.; Erdogan, Y. Investigation of antimicrobial activities of nonanoic acid derivatives. Fresenius Environmental Bulletin, 2006, 15(2), 141-143.
- Pantel, L.; Florin, T.; Dobosz-Bartoszek, M.; Racine, E.; Sarciaux, M.; Serri, M.; Houard, J.; Campagne, J.-M.; de Figueiredo, R.M.; Midrier, C.; et al. Odilorhabdins, Antibacterial Agents that Cause Miscoding by Binding at a New Ribosomal Site. Mol. Cell 2018, 70, 83–94.e7. [CrossRef]
- Reimer, D.; Luxenburger, E.; Brachmann, A.O.; Bode, H.B. A New Type of Pyrrolidine Biosynthesis Is Involved in the Late Steps of Xenocoumacin Production in Xenorhabdus nematophila. ChemBioChem 2009, 10, 1997–2001. [CrossRef]
- Gad, H.A.; Mukhammadiev, E.A.; Zengen, G.; Al Musayeib, N.M.; Hussain, H.; Bin Ware, I.; Ashour, M.L.; Mamadalieva, N.Z. Chemometric Analysis Based on GC-MS Chemical Profiles of Three Stachys Species from Uzbekistan and Their Biological Activity. Plants 2022, 11, 1215. [CrossRef]
- Taher, M.A.; Laboni, A.A.; Shompa, S.A.; Rahman, M.; Hasan, M.M.; Hasnat, H.; Khan, M. Bioactive compounds extracted from leaves of G. cyanocarpa using various solvents in chromatographic separation showed anti-cancer and anti-microbial potentiality in in silico approach. Chin. J. Anal. Chem. 2023, 51. [CrossRef]
- Baiome, B.A.; Ye, X.; Yuan, Z.; Gaafar, Y.Z.A.; Melak, S.; Cao, H. Identification of Volatile Organic Compounds Produced by Xenorhabdus indica Strain AB and Investigation of Their Antifungal Activities. Appl. Environ. Microbiol. 2022, 88, e0015522. [CrossRef]
- Karthik, Y.; Kalyani, M.I.; Krishnappa, S.; Devappa, R.; Goud, C.A.; Ramakrishna, K.; Wani, M.A.; Alkafafy, M.; Abduljabbar, M.H.; Alswat, A.S.; et al. Antiproliferative activity of antimicrobial peptides and bioactive compounds from the mangrove Glutamicibacter mysorens. Front. Microbiol. 2023, 14, 1096826. [CrossRef]
- Hawar, S.N.; Taha, Z.K.; Hamied, A.S.; Al-Shmgani, H.S.; Sulaiman, G.M.; Elsilk, S.E. Antifungal Activity of Bioactive Compounds Produced by the Endophytic Fungus Paecilomyces sp. (JN227071.1) against Rhizoctonia solani. Int. J. Biomater. 2023, 2023, 1–8. [CrossRef]
- Awori, R.M. Nematophilic bacteria associated with entomopathogenic nematodes and drug development of their biomolecules. Front. Microbiol. 2022, 13, 993688. [CrossRef]
- Joyce, S.A.; Lango, L.; Clarke, D.J. The regulation of secondary metabolism and mutualism in the insect pathogenic bacterium Photorhabdus luminescens. In Advances in applied microbiology, 2011, 76: 1-25). Academic Press.
- Breijyeh, Z.; Karaman, R. Design and Synthesis of Novel Antimicrobial Agents. Antibiotics 2023, 12, 628. [CrossRef]
- Sanda, N.B.; Hou, Y. The Symbiotic Bacteria—Xenorhabdus nematophila All and Photorhabdus luminescens H06 Strongly Affected the Phenoloxidase Activation of Nipa Palm Hispid, Octodonta nipae (Coleoptera: Chrysomelidae) Larvae. Pathogens 2023, 12, 506.
- Abdel-Wareth, M.T.A.; Ali, E.A.M.; El-Shazly, M.A. (2023). Biological Activity and GC-MS/MS Analysis of Extracts of Endophytic Fungi Isolated from Eichhornia crassipes (Mart.) Solms. Journal of Applied Biotechnology Reports, 2023, 10(1), 895-909.
- Yellamanda, B.; Vijayalakshmi, M.; Kavitha, A.; Reddy, D.K.; Venkateswarlu, Y. Extraction and bioactive profile of the compounds produced by Rhodococcus sp. VLD-10. 3 Biotech. 2016 (2):261.
- Sato, K.; Yoshiga, T.; Hasegawa, K. Involvement of Vitamin B 6 Biosynthesis Pathways in the Insecticidal Activity of Photorhabdus luminescens. Appl. Environ. Microbiol. 2016, 82, 3546–3553. [CrossRef]
- Abdel-Wareth, M.T.A.; Ali, E.A.M.; El-Shazly, M.A. Biological Activity and GC-MS/MS Analysis of Extracts of Endophytic Fungi Isolated from Eichhornia crassipes (Mart.) Solms. Journal of Applied Biotechnology Reports, 2023, 10(1), 895-909.
- Koilybayeva, M.; Shynykul, Z.; Ustenova, G.; Abzaliyeva, S.; Alimzhanova, M.; Amirkhanova, A.; Turgumbayeva, A.; Mustafina, K.; Yeleken, G.; Raganina, K.; et al. Molecular Characterization of Some Bacillus Species from Vegetables and Evaluation of Their Antimicrobial and Antibiotic Potency. Molecules 2023, 28, 3210. [CrossRef]
- Farag, M.A.; Gad, M.Z. Omega-9 fatty acids: potential roles in inflammation and cancer management. J. Genet. Eng. Biotechnol. 2022, 20, 48–11. [CrossRef]
- Sangeetha, B.G.; Jayaprakas, C.A.; Siji, J.V.; Rajitha, M.; Shyni, B.; Mohandas, C. Molecular characterization and amplified ribosomal DNA restriction analysis of entomopathogenic bacteria associated with Rhabditis (Oscheius) spp.. 3 Biotech 2016, 6, 32. [CrossRef]
- Forst, S.; Nealson, K. 1996. Molecular Biology of the Symbiotic-Pathogenic Bacteria Xenorhabdus spp. and Photorhabdus spp. Microbiol. Rev.1996, 60: 21-43.
- Clarke, D.J. Photorhabdus: a model for the analysis of pathogenicity and mutualism. Cell. Microbiol. 2008, 10, 2159–2167. [CrossRef]
- Dreyer, J.; Malan, A.P.; Dicks, L.M.T. Bacteria of the Genus Xenorhabdus, a Novel Source of Bioactive Compounds. Front. Microbiol. 2018, 9, 3177. [CrossRef]
- Priyadarshini, S.; Gopinath, V.; Priyadharsshini, N.M.; MubarakAli, D.; Velusamy, P. Synthesis of anisotropic silver nanoparticles using novel strain, Bacillus flexus and its biomedical application. Colloids Surfaces B: Biointerfaces 2013, 102, 232–237. [CrossRef]
- San-Blas, E.; Cubillán, N.; Guerra, M.; Portillo, E.; Esteves, I. Characterization of Xenorhabdus and Photorhabdus bacteria by Fourier transform mid-infrared spectroscopy with attenuated total reflection (FT-IR/ATR). Spectrochim. Acta Part A: Mol. Biomol. Spectrosc. 2012, 93, 58–62. [CrossRef]
- Gopinath, K.; Gowri, S.; Arumugam, A. 2013. Phytosynthesis of silver nanoparticles using Pterocar pussantalinus leaf extract and their antibacterial properties. J. Nanostructure Chem. 2013, 3: 68.
- Cimen, H.; Touray, M.; Gulsen, S.H.; Erincik, O.; Wenski, S.L.; Bode, H.B.; Shapiro-Ilan, D.; Hazir, S. Antifungal activity of different Xenorhabdus and Photorhabdus species against various fungal phytopathogens and identification of the antifungal compounds from X. szentirmaii. Appl. Microbiol. Biotechnol. 2021, 105, 5517–5528. [CrossRef]
- Paul, V.J.; Frautschy, S.; Fenical, W.; Nealson, K.H. Antibiotic in microbial ecology, isolation and structure assignment of several new antibacterial compounds from the insect-symbiotic bacteria Xenorhabdus spp. J. Chem. Ecol. 1981, 589-597.
- Elbrense, H.; Elmasry, A.M.A.; Seleiman, M.F.; Al-Harbi, M.S.; El-Raheem, A.M.A. Can Symbiotic Bacteria (Xenorhabdus and Photorhabdus) Be More Efficient than Their Entomopathogenic Nematodes against Pieris rapae and Pentodon algerinus Larvae?. Biology 2021, 10, 999. [CrossRef]
- Brachmann, A.O.; Bode, H.B. Identification and Bioanalysis of Natural Products from Insect Symbionts and Pathogens. In Yellow Biotechnology I; Advances in Biochemical Engineering/Biotechnology; Springer: Berlin/Heidelberg, Germany, 2013; Volume 135, pp. 123–155. [CrossRef]
- Parihar, R.D.; Dhiman, U.; Bhushan, A.; Gupta, P.K.; Gupta, P. Heterorhabditis and Photorhabdus Symbiosis: A Natural Mine of Bioactive Compounds. Front. Microbiol. 2022, 13, 790339. [CrossRef]
- Koilybayeva, M.; Shynykul, Z.; Ustenova, G.; Abzaliyeva, S.; Alimzhanova, M.; Amirkhanova, A.; Turgumbayeva, A.; Mustafina, K.; Yeleken, G.; Raganina, K.; et al. Molecular Characterization of Some Bacillus Species from Vegetables and Evaluation of Their Antimicrobial and Antibiotic Potency. Molecules 2023, 28, 3210. [CrossRef]
- Mollah, M.I.; Kim, Y. Virulent secondary metabolites of entomopathogenic bacteria genera, Xenorhabdus and Photorhabdus, inhibit phospholipase A2 to suppress host insect immunity. BMC Microbiol. 2020, 20, 1–13. [CrossRef]
- Gulsen, S.H.; Tileklioglu, E.; Bode, E.; Cimen, H.; Ertabaklar, H.; Ulug, D.; Ertug, S.; Wenski, S.L.; Touray, M.; Hazir, C.; et al. Antiprotozoal activity of different Xenorhabdus and Photorhabdus bacterial secondary metabolites and identification of bioactive compounds using the easyPACId approach. Sci. Rep. 2022, 12, 10779. [CrossRef]
- Isaacson, P.; Webster, J. Antimicrobial activity of Xenorhabdus sp. RIO (Enterobacteriaceae), symbiont of the entomopathogenic nematode, Steinernema riobrave (Rhabditida: Steinernematidae). J. Invertebr. Pathol. 2002, 79, 146–153. [CrossRef]
- Li, J.; Chen, G.; Webster, J.M.; Czyzewska, E. Antimicrobial Metabolites from a Bacterial Symbiont. J. Nat. Prod. 1995, 58, 1081–1086. [CrossRef]
- Thaler, J.O.; Baghdiguian, S.; Boemare, N.E. Purification and characterization of nematophilicin, phage tail like bacteriocin, from the lysogenic strain FI of Xenorhabdus nematophilus. Appl. Environ. Microbiol. 1995, 61: 2049-2052.
- Muangpat, P.; Yooyangket, T.; Fukruksa, C.; Suwannaroj, M.; Yimthin, T.; Sitthisak, S.; Chantratita, N.; Vitta, A.; Tobias, N.J.; Bode, H.B.; et al. Screening of the Antimicrobial Activity against Drug Resistant Bacteria of Photorhabdus and Xenorhabdus Associated with Entomopathogenic Nematodes from Mae Wong National Park, Thailand. Front. Microbiol. 2017, 8, 1142. [CrossRef]
- Muangpat, P.; Suwannaroj, M.; Yimthin, T.; Fukruksa, C.; Sitthisak, S.; Chantratita, N.; Vitta, A.; Thanwisai, A. Antibacterial activity of Xenorhabdus and Photorhabdus isolated from entomopathogenic nematodes against antibiotic-resistant bacteria. PLOS ONE 2020, 15, e0234129. [CrossRef]
- León-Buitimea, A.; Garza-Cárdenas, C.R.; Garza-Cervantes, J.A.; Lerma-Escalera, J.A.; Morones-Ramírez, J.R. The Demand for New Antibiotics: Antimicrobial Peptides, Nanoparticles, and Combinatorial Therapies as Future Strategies in Antibacterial Agent Design. Front. Microbiol. 2020, 11, 1669. [CrossRef]
- Le, C.-F.; Fang, C.-M.; Sekaran, S.D. Intracellular Targeting Mechanisms by Antimicrobial Peptides. Antimicrob. Agents Chemother. 2017, 61, e02340-16. [CrossRef]
- Hu, K.; Li, J.; Li, B.; Webster, J.M.; Chen, G. A novel antimicrobial epoxide isolated from larval Galleria mellonella infected by the nematode symbiont, Photorhabdus luminescens (Enterobacteriaceae). Bioorganic Med. Chem. 2006, 14, 4677–4681. [CrossRef]
- Booysen, E.; Dicks, L.M.T. Does the Future of Antibiotics Lie in Secondary Metabolites Produced by Xenorhabdus spp.? A Review. Probiotics Antimicrob. Proteins 2020, 12, 1310–1320. [CrossRef]
- Boszormenyi, E.; Ersek, T.; Fodor, A.; Fodor, A.M.; Foldes, L.S.; Hevesi, M.; et al. Isolation and activity of Xenorhabdus antimicrobial compounds against the plant pathogens Erwinia amylovora and Phytophthora nicotianae. J. Appl. Microbiol. 2009, 107: 764-759.
- Furgani, G.; Böszörményi, E.; Fodor, A.; Máthé-Fodor, A.; Forst, S.; Hogan, J.; Katona, Z.; Klein, M.; Stackebrandt, E.; Szentirmai, A.; et al. Xenorhabdus antibiotics: a comparative analysis and potential utility for controlling mastitis caused by bacteria. J. Appl. Microbiol. 2008, 104, 745–758. [CrossRef]
- Seo, S.; Kim, Y. 2011. Development of “Bt-Plus” biopesticide using entomopathogenic bacteria (Xenorhabdus nematophila, Photorhabdus temperata ssp. temperata) metabolites. Korean J. Appl. Entomol. 2011, 50: 171-178.
- Kanost, M.R.; Jiang, H.; Yu, X. Innate immune responses of a lepidopteran insect, Manduca sexta. Immunol. Rev. 2004, 198, 97–105. [CrossRef]
- Orozco, R.A.; Molnár, I.; Bode, H.; Stock, S.P. Bioprospecting for secondary metabolites in the entomopathogenic bacterium Photorhabdus luminescens subsp. sonorensis. J. Invertebr. Pathol. 2016, 141, 45–52. [CrossRef]
- Watson, R.J.; Millichap, P.; Joyce, S.; Reynolds, S.; Clarke, D. The role of iron uptake in pathogenicity and symbiosis in Photorhabdus luminescens TT01. BMC Microbiol. 2010, 10: 177.
- Akhurst, R.J. Morphological and Functional Dimorphism in Xenorhabdus spp., Bacteria Symbiotically Associated with the Insect Pathogenic Nematodes Neoaplectana and Heterorhabditis. J. General Microbiology 1980, 121, 303–309. [CrossRef]
- Tailliez, P.; Pagès, S.; Ginibre, N.; Boemare, N. New insight into diversity in the genus Xenorhabdus, including the description of ten novel species. Int. J. Syst. Evol. Microbiol. 2006, 56, 2805–2818. [CrossRef]
- Chandrakasan, G.; Ayala, M.T.; Trejo, J.F.G.; Marcus, G.; Maruthupandy, M.; Kanisha, C.C.; Murugan, M.; Al-Mekhlafi, F.A.; Wadaan, M.A. Bio controlled efficacy of Bacillus thuringiensis cry protein protection against tomato fruit borer Helicoverpa armigera in a laboratory environment. Physiol. Mol. Plant Pathol. 2022, 119. [CrossRef]
- Forst, S.; Clarke, D. Bacteria-nematode symbiosis. In Entomopathogenic nematology, 2002, pp. 57-77. CABI Publishing, CAB International, Wallingford, UK.
- Shapiro-Ilan, D.I.; Cottrell, T.E.; Gardner, W.A.; Behle, R.W.; Ree, B.; Harris, M.K. Efficacy of Entomopathogenic Fungi in Suppressing Pecan Weevil,Curculio caryae(Coleoptera: Curculionidae), in Commercial Pecan Orchards. Southwest. Èntomol. 2009, 34, 111–120. [CrossRef]
- Cappuccino, J.G.; Sherman, N. Microbiology: a laboratory manual, 2002, pp. 263-264. Benjamin, Harlow.
- Bonev, B.; Hooper, J.; Parisot, J. Principles of assessing bacterial susceptibility to antibiotics using the agar diffusion method. J. Antimicrob. Chemother. 2008, 61, 1295–1301. [CrossRef]

| Sampling site | Agriculture crops/ land |
Recovered | Soil Type | Soil Temperature (oC) | Organic content (%) | pH | Electrical conductivity (mS/cm) | Symbiotic bacteria characteristics | |||
|---|---|---|---|---|---|---|---|---|---|---|---|
| Steinernema spp. | Heterorhabditis spp. | ||||||||||
| Xenorhabdus spp(Amz 05) | Photorhabdus spp(Amz 10) | ||||||||||
|
Zone I (agricultural land) |
Corn | ++ | - | sandy | 29 | 4.9 | 7.25 | 0.93 | Blue color colony | Greenish yellow color coloy | |
| Rice | - | ++ | Loam clay | 31 | 4.8 | 7.13 | 1.29 | Bioluminescence (-)tive |
Bioluminescence (+)tive | ||
| wheat | ++ | - | loam | 30 | 3.9 | 7.40 | 1.32 | Catalase (-) tive | Catalase (+) tive | ||
|
Zone II (uncultured land) |
Forest | + | - | Silt | 28 | 4.9 | 7.70 | 1.74 | Absorption of bromothymol blue | Absorption of bromothymol blue | |
| Grasses | + | - | Silt | 29 | 3.8 | 7.41 | 1.59 | Growth on 28oC | Growth on 28oC | ||
| Waste land | - | Silt | 30 | 4.1 | 7.23 | 1.03 | Insect pathogenicity | Insect pathogenicity | |||
| S. No. | FT-IR peaks (cm-1) | Possible assigned functional groups |
|---|---|---|
| 1 | 3443 | Amine, N-H Stretch |
| 2 | 1637 | NH amide bend C-Br Bend |
| 3 | 1100 | ANAH and carbonyl (CAOA) |
| 4 | 621 | Carbonyl stretching (OC) |
| S. No. | FT-IR peaks (cm-1) | Possible assigned functional groups |
|---|---|---|
| 1 | 3436 | Amine, N-H Stretch |
| 2 | 2078 | C≡N, Nitriles |
| 3 | 1078 | Carbonyl stretch |
| 4 | 692 | Alkyl Halides |
| Tested organisms | Zone of Inhibition (cm) | ||||
|---|---|---|---|---|---|
| X. stockiae | P. luminescens | Positive control | |||
| A | B | C | D | ||
| 1. Escherichia coli | 2.6 ± 0.7 | 2.9± 0.7 | 2.1 ±0.8 | 2.4±0.8 | 3.1 ± 0.7 |
| 2.Staphylococcus aureus | 2.5 ± 0.6 | 2.8 ± 0.6 | 1.9 ± 0.6 | 2.0± 0.6 | 2.9 ± 0.6 |
| 3. Enterococcus faceium | 2.2 ± 0.2 | 2.5 ± 0.2 | 1.8 ± 0.4 | 2.2 ± 0.4 | 2.7 ± 0.2 |
| 4. Proteus vulgaris | 2.1 ± 0.3 | 2.4 ± 0.3 | 1.7 ± 0.8 | 2.0 ± 0.8 | 2.7 ± 0.3 |
| 5. Bacillus cereus | 2.0± 0.9 | 2.3± 0.9 | 1.6 ± 0.4 | 1.9 ± 0.4 | 2.6± 0.9 |
| 6. Bacillus subtilis | 1.9± 0.9 | 2.1± 0.9 | 1.5 ± 0.8 | 1.8 ± 0.8 | 2.6± 0.9 |
Disclaimer/Publisher’s Note: The statements, opinions and data contained in all publications are solely those of the individual author(s) and contributor(s) and not of MDPI and/or the editor(s). MDPI and/or the editor(s) disclaim responsibility for any injury to people or property resulting from any ideas, methods, instructions or products referred to in the content. |
© 2024 by the authors. Licensee MDPI, Basel, Switzerland. This article is an open access article distributed under the terms and conditions of the Creative Commons Attribution (CC BY) license (http://creativecommons.org/licenses/by/4.0/).